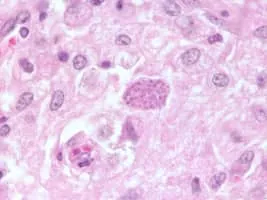

Neospora
| Use attributes for filter ! | |
| Scientific name | Neospora |
|---|---|
| Rank | Genus |
| Higher classification | Toxoplasmatinae |
| Family | Sarcocystidae |
| Phylum | Apicomplexa |
| Class | Conoidasida |
| Date of Reg. | |
| Date of Upd. | |
| ID | 2271170 |
About Neospora
Neospora is a single celled parasite of livestock and companion animals. It was not discovered until 1984 in Norway, where it was found in dogs. Neosporosis, the disease that affects cattle and companion animals, has a worldwide distribution. Neosporosis causes abortions in cattle and paralysis in companion animals.